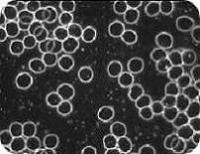
Dunkelfeld

Dunkelfeldmikroskopie
Naturheilkundliche Betrachtung des Blutes
Die Dunkelfeldmikroskopie ist eine naturheilkundliche Betrachtungsmethode, bei der ein frischer Tropfen Kapillarblut unter dem Dunkelfeldmikroskop angeschaut wird. Dabei steht die Beobachtung der Blutzellen und des Blutplasmas im Vordergrund.Diese Methode ermöglicht es, das Blut in seiner momentanen Erscheinungsform zu betrachten und Veränderungen im Blutmilieu sichtbar zu machen. Die Betrachtung erfolgt ergänzend und orientierend im Rahmen der naturheilkundlichen Beratung.

Ablauf der Dunkelfeldbetrachtung
Für die Dunkelfeldmikroskopie genügt ein kleiner Tropfen Blut aus der Fingerbeere. Der Bluttropfen wird unmittelbar unter dem Mikroskop betrachtet.Die Beobachtung kann gemeinsam über einen Bildschirm erfolgen, sodass Sie einen direkten Eindruck von der Darstellung Ihres Blutes erhalten.
Im Fokus stehen dabei unter anderem:
- die Erscheinungsform der roten Blutkörperchen
- das Verhältnis von Zellen und Plasma
- Strukturen und Bewegungsmuster im Blut
Einordnung der Methode
Die Dunkelfeldmikroskopie dient der naturheilkundlichen Einschätzung des Blutmilieus und wird in der Erfahrungsmedizin als ergänzende Betrachtungsmethode eingesetzt.Sie ersetzt keine schulmedizinische Diagnostik, keine Laboruntersuchungen und keine ärztliche Abklärung.
Die Ergebnisse werden nicht diagnostisch, sondern orientierend genutzt und fließen in die ganzheitliche Beratung ein.
Historischer Hintergrund
Die Betrachtungsweise des Blutes im Dunkelfeldmikroskop geht auf den MedizinerProf. Dr. Günther Enderlein (1872–1968) zurück und wird bis heute im Bereich der naturheilkundlichen Erfahrungsmedizin angewendet.


